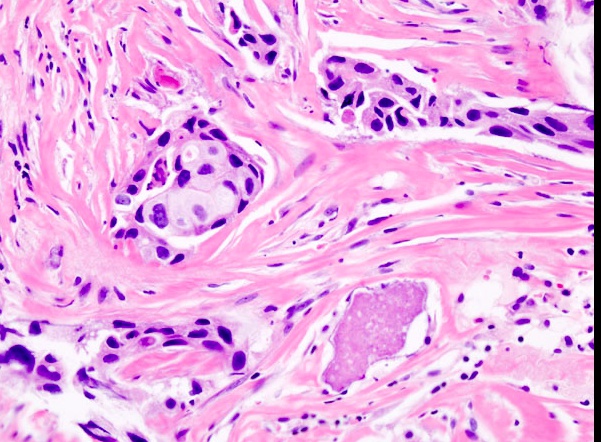

Breast Disorders
Overview
Risks

African American: more at risk for Her2 negative
Diagnosis
US: useful for women under 30 or pregnant as tissues are denser, more fibrous
simple cyst: observe
growing cyst: aspirate
bloody aspirate: cytology
solid cyst: biopsy with core needle rather than surgical
MRI: not needed unless unsure. High false positive
mammogram: over 30 with new masss. Core needle biopsy next
Tumor markers not used since poor sensitivity/specificity

Metastatic Workup
liver chemistry
Bone: alk phos, calcium
x ray: pulmonary mets
abd/chest CT not needed
Staging

T: size of tumor, depth of invasion
N: spread to regional lymph
M: met remotely
stage 3: large tumors, > 5 cm, invaded skin (inflammatory), large axillary lymph
Management
Stage 1 and 2:
breast conserving therapy (BCT): lumpectomy, sentinel lymph node biopsy (SLNB), radiation therapy
CI: multiple tumors in 2 mor more quandrants, diffise malignant microcalcifications, previous chest wall radiation, positive surgical margins despite excision, early pregnancy
simple mastectomy
Stage 3:
simple mastectomy
ALND (axillary lymph node dissection)
ALND:
Used for staging and not therapeutic
performed if more than 2 positive SLNB or in pts who underwent mastectomy
boundaries: axillary vein superiorly, floor of axilla posteriorly, latissimus dorsi laterally, pec minor medially.


Complications

Ductal vs Lobular
_..
_The appearance of hard nodule or dimpling of the skin are potential signs of an underlying adenocarcinoma
cancer in lobules: tug on suspensory lig = dimples
cancer in ducts: tug on ducts = inverted nipple
If a DCIS extends to lactiferous ducts and areolar skin, then an underlying invasive ductal carcinoma is often present..


Benign

_Fibroadenoma: non tender on palpation
Fibrocystic change: tender on palpation.
Fibrocystic Change
_ a condition characterized by the development of fibrosis and cysts in the breast. It is the most common change in the premenopausal breast, and it is thought to be hormone mediated.,
Normal breast variation due to estrogen/progesterone
Clinical hallmarks of fibrocystic change: age >25 years old, midcycle tenderness, multiple lumps bilaterally. Lumpy breasts.
_The clinical presentation is a vague irregularity of the breast tissue that is usually in the upper outer quadrant. It also includes the following findings:
Multiple, often bilateral lumps
Nodularities exhibit midcycle tenderness (suggesting it is hormone-mediated)
Most often occurs in upper-outer quadrants
Cysts have a blue-dome appearance on gross exam.,
lumpy breast
not really a mass

_There are three forms of that do not carry an increased risk of cancer, these include the following:
Fibrosis: hyperplasia of breast stroma or cyst rupture.
Cysts: fluid-filled with drainage that confirms it as a cyst; hemorrhagic fluid appears blue through wall ("blue dome cyst").
Apocrine metaplasia: large, eosinophilic cells with scalloping border.,
_There are three forms that carry an increased risk of cancer, these include the following:
Sclerosing adenosis: well-circumscribed swirling and crowding of ducts/acini within a lobule; associated with fibrotic stroma and microcalcifications.
Ductal hyperplasia
Atypical/Epithelial hyperplasia (ductal or lobular): due to estrogen stimulation; cells contain acquired genetic defects found in carcinoma, and is very similar in appearance to carcinoma in situ.,
sclerosing adenosis: too many glands with fibrosis = hard with collagen
calcification possible
ductal: atypical, atypical ductal hyperplasia and atypical lobular hyperplasia:

In short, apocrine metaplasia has no increased risk for cancer. Ductal hyperplasia or sclerosing adenosis doubles the risk of cancer development. Atypical hyperplasia has the highest risk for cancer.
Acute Mastitis
_Commonly occurs with bacterial infection of the breast, and it is most commonly due to Staphylococcus aureus. It is commonly associated with breastfeeding; especially in small fissures that develop in the nipple providing a route of entry for microbes.,
_Will clinically present as an erythematous breast with purulent nipple discharge; may progress to abscess formation.,

The treatment of acute mastitis involves continued drainage (e.g. breast feeding) and antibiotics (e.g. dicloxacillin).
May be inflammatory carcinoma if not improve with antibiotics
Periductal mastitis
_Is a condition commonly seen in smokers that occurs when there is inflammation of the subareolar ducts.
The pathogenesis is believed to be from a relative Vitamin A deficiency., This results in squamous metaplasia of lactiferous ducts, producing duct blockage and inflammation.
Highly specialized epithelium dependent on vit a. With vit a deficiency, epithelium becomes squamous metaplasia, keratinize, blocks duct, and becomes inflamed.
_The clinical presentation will commonly be a subareolar mass with nipple retraction..
mass+fibrosis = myofibroblast contract and pull in skin
Also seen in IDC, invasive ductal carcinoma
Mammary duct ectasia
_Is a rare condition classically seen in multiparous postmenopausal women that occurs with inflammation and dilation of the subareolar ducts. (actually not cancer because of discharge)
The clinical presentation is a periareolar mass with brown, green, or white nipple discharge (inflammatory debris). Biopsy will reveal chronic inflammation with plasma cells.,
important, aka plasma cell mastitis
inflammation
dilation of ducts
debrid pile up
piled up debris goes out of nipple = green/brown
can be a mass in breast..

Fat Necrosis
_A benign condition that commonly occurs with trauma to the breast, however a history of trauma may not always be evident.
It will commonly present as painless lump on physical exam or abnormal calcification on mammography (due to saponification).,
Usually fat necrosis can be enzymatic or trauma. Enzymatic e.g. pancreatitis. Trauma eg. breast. hit in chest with ball something simple
Biopsy of the breast tissue will demonstrate necrotic fat with associated calcification and giant cells.
Gynecomastia
_Drugs causing symptoms can be remembered with the mnemonic Some Drugs Create Awesome Knockers:
Spironolactone
Ketoconazole
Digitalis
Cimetidine
Alcohol..
_Bloody discharge:
Benign: intraductal papilloma (most common cause)
Malignant: ductal carcinoma in situ, invasive ductal carcinoma, or papillary carcinoma..
_sclerosing adnosis, fat necrosis, DCIS..
Intraductal Papilloma
_Is a benign papillary growth, usually into a large lactiferous duct, and it is the most common cause of bloody nipple discharge in premenopausal women (<50).,
_Is characterized by fibrovascular projections lined by epithelial (luminal) and myoepithelial cells..
Contrast this with papillary carcinoma (also bloody discharge), where fibrovascular projections possess epithelial cells without underlying myoepithelial cells. The risk of papillary carcinoma increases with age, thus, it is more commonly seen in postmenopausal women.

both layers of cells
myoepithelial: contractile
luminal: milk production



Fibroadenoma
_is a benign tumor of fibrous tissue and glands that is the most common benign neoplasm of the breast. It most commonly occurs in women in their 20s and 30s.,

_The clinical presentation includes:
Painless (less commonly painful) and well circumscribed: distinct from rest of breast
Mobile marble-like mass, smooth, firm
Estrogen-sensitive (grows during pregnancy, and may be painful during the menstrual cycle, shrink during menopause)
May involute or calcify after menopause.,
_The gross appearance of fibroadenomas presents as a well-circumscribed, grayish-white, rubbery nodule with cleft-like spaces inside.,
Fibroadenoma: noncalcified rounded mass in UOQ left breast

Wider than tall
breast cancer grow vertical
_On histology, characterized by a proliferation of intralobular stroma. Duct epithelium does not show signs of neoplasia, but may appear as a distorted by mass invasion.,
Fibroadenomas are small, firm, and mobile breast masses that occur due to proliferation of breast stroma and ducts, with stromal proliferation compressing the ducts to slits (black arrow) on microscopic examination.
sharply demarcated fibrosis and glands
_Associated with cyclosporin A usage., Half of women receiving cyclosporine (e.g. renal transplantation) develop fibroadenomas and often present with multiple, bilateral tumors.
_Are benign, and do not carry an increased risk of carcinoma. The transformation of fibroadenomas into a malignant breast cancer is extremely rare. Management is generally conservative observation..
Phyllodes
_fibroadenoma-like tumors with overgrowth of the fibrous component, and they most commonly seen in postmenopausal women (>50)..

_Gross are characterized by a large, bulky, stromal mass of connective tissue and cysts.

On histological examination, characterized by cystic spaces containing leaf-like projections from the cyst walls and myxoid contents

pushing tumor out.,
_Can be malignant (cystosarcoma phyllodes). This can be observed via histological examination which will reveal hypercellularity and mitoses..
Malignant Mammary Disorders

_Breast cancer is the most common cancer by incidence in women in the United States (excluding skin cancer). It is the second most common cause of cancer mortality in women..
_Breast carcinomas may arise from mammary and duct epithelium or lobular glands..
DCIS
_is the most common post-menopausal breast carcinoma. A breast mass in a woman older than 50 should be considered a carcinoma until proven otherwise.,
_Ductal Carcinoma in situ..
_Ductal carcinoma in situ (DCIS) is a malignant proliferation of cells in ducts with no invasion of the basement membrane..
Bound by basement membrane If blocked up and goes to nipple = paget If invade = invasive DC
Or could be lobular or invasive lobular
_Does not usually produce a mass, but is often detected as calcification on mammography. Mammographic calcifications can also be associated with benign conditions such as fibrocystic changes (especially sclerosing adenosis) and fat necrosis. Thus, it is important to biopsy the calcifications to distinguish between benign and malignant conditions..
no blood in center of duct > necrosis > dystrophic calcification
_Histological are based on architecture; the comedo type is characterized by high-grade cells with necrosis and dystrophic calcification in the center of ducts.,
Paget disease
_DCIS that has extended up the ducts to involve the skin of the nipple.
This will present as nipple ulceration and erythema. Paget disease of the breast is almost always associated with an underlying carcinoma. It is characterized by a eczematoid lesion of the nipple or areola. Gross examination may reveal a rash with possible nipple retraction..
Invasive Ductal Carcinoma
_is the most common type of invasive carcinoma in the breast (>80% of cases), and will classically form duct-like structures., Round ducts
_Individuals present with a mass detectable by physical exam or mammography.
Clinically detectable masses are usually 2 cm or greater
Mammographically detectable masses are usually 1 cm or greater
Advanced tumors may result in dimpling of the skin or retraction of the nipple.,
_Biopsy shows duct-like structures in a desmoplastic stroma. The gross appearance reveals a gray-white tumor with stellate morphology, and reactive fibroplasia (desmoplasia) leads to a gritty induration.
.,
_There are four specialized subtypes, and they carry a better prognosis than a pure invasive ductal carcinoma. These include:
Tubular carcinoma
Mucinous carcinoma
Medullary carcinoma
Inflammatory carcinoma (poor prognosis).,
From top left to bottom right: ductal NST, medullary, tubular, cribriform, mucinous and (squamous) metaplastic breast cancer.
Tubular Carcinoma
_Is characterized by well-differentiated tubules that lack myoepithelial cells and may develop bilaterally. These carry a relatively good prognosis.,
looks like breast
desmoplastic stroma
Mucinous carcinoma
_Aka colloid.,
_Characterized by clusters of tumor cells floating in mucin. Mucinous carcinomas tend to affect elderly women (average age is 70 years). These carry a relatively good prognosis.,
stuck in mucous, can't go anywhere = good prognosis
Medullary Carcinoma
_Is characterized by large, high-grade cells growing in sheets with associated lymphocytes and plasma cells. These tend to grow as a well-circumscribed mass that can resemble a fibroadenoma on mammography. Have a relatively good prognosis.,
increased risk for medullary carcinoma and serous carcinoma of fallopian tube and ovary
_These are associated with BRCA1 carriers.,
Inflammatory Carcinoma
_Iis characterized by carcinoma in dermal lymphatics. These will classically present as an inflamed, swollen breast (tumor cells block drainage of lymphatics) with no discrete mass; can be mistaken for mastitis. The appearance is commonly referred to as "Peau d'orange," because the cutaneous lymphatic edema gives the skin a dimpled texture like that of an orange peel. These carry a poor prognosis.,
can be mistaken for acute mastitis: if antibiotic does not resolve gross: swollen breast poor prognosis: already have access to lymph
LCIS
_Lobular carcinoma in situ..
_Is a malignant proliferation of cells in lobules with no invasion of the basement membrane. LCIS does not produce a mass or calcifications, and is usually discovered incidentally on biopsy. They are often multifocal and bilateral.,
_Is characterized by cells lacking the E-cadherin adhesion protein, causing a separation of cells., Invasive lobular carcinoma also lacks the E-cadherin adhesion protein.
cells not stuck to one another
_The treatment includes tamoxifen (to reduce the risk of subsequent carcinoma) and also close monitoring. These lesions have a low risk of progression to invasive carcinoma..
Invasive Lobular
_Is a malignant proliferation that characteristically grows in a "Indian-file" pattern, where cells align in a linear or bulls-eye arrangement.
.,
Similarly to LCIS, invasive lobular carcinoma can appear multifocal or bilateral, and lack duct formation due to the absence of E-cadherin.
Risks
_There are many risk factors for breast cancer, and most of which are related to estrogen exposure. These include:
Age (cancer usually arises in postmenopausal women, with the notable exception of hereditary breast cancer)
Female gender
Early menarche/late menopause (prolonged estrogen stimulation)
Obesity
Atypical ductal hyperplasia (fibrocystic change) (prior biopsy showing hyperplasia = usually due to estrogen stimulation)
First degree relative with breast cancer..
_There is a significant influence of genetics (involved in 10% of cases) and family history contribution to the development of breast cancer. The following mutations have been identified:
BRCA1
BRCA2 (male breast carcinoma)
p53 (Li-Fraumeni)
Rb
HER-2/neu (c-erb-β2)..
_The risk for breast carcinoma is not increased by fibroadenoma or non-hyperplastic cysts..
_Occurs most frequently in the upper outer quadrant of the breast. The most important prognostic factor in breast cancer is whether or not they have metastasized to the axillary nodes. A sentinel node biopsy is used to assess axillary lymph nodes. Metastasis to the internal mammary lymph nodes is most common in medial (vs. lateral) tumors..
inject dye into breast, biopsy first node most important factor: metastasis. Most patient not metastasis, thus check axillary
_The overexpression of ER/PR (estrogen/progesterone receptors) or HER-2/neu (c-erb-β2, an EGF receptor) is common and can help aid in therapy and prognosis..
ER/PR-positive tumors can be treated with tamoxifen, and carry a better prognosis.
HER-2/neu (c-erb-β2) is a proto-oncogene that exhibits gene amplification and can be treated with trastuzumab, an antibody directed against the HER-2 receptor.
ER, Receptors in nucleus:
Her2, receptor on cell membrane
_Individuals (most commonly African American women) with tumors negative for ER, PR, and HER-2/neu are termed "triple-negative" and have a poor prognosis..
_Male breast cancer is much more rare (1% of all breast cancers), and most common histological subtype is invasive ductal carcinoma. Lobular carcinoma is rare because the male breast develops very few lobules..
_Male breast cancer usually presents with nipple discharge and a subareolar mass (most male breast tissue is underneath the nipple) in older individuals. Males develop terminal ducts but not lobules..
_Male breast cancer is associated with the BRCA2 mutations and Klinefelter syndrome..
Breast metastases
_Often goes to lung, liver, bone..
Last updated
Was this helpful?